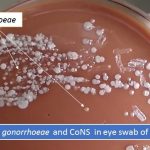
Neisseria gonorrhoeae and Cons in eye swab of neonate

Collection Group: Clinical Bacteriology
Coryneform Bacteria in Gram Stain: Introduction, Morphology, Lab Diagnosis and Treatment
 Coryneform bacteria in Gram stain Coryneform bacteria bacilli or rods...
Coryneform bacteria in Gram stain Coryneform bacteria bacilli or rods...
SIM Test for Gram Negative Bacteria: Introduction, Principle, Procedure, Result Interpretation
 Introduction of SIM Test SIM test stands for sulphide, indole,...
Introduction of SIM Test SIM test stands for sulphide, indole,...
Ophthalmia neonatorum: Introduction, Pathogens and Prevention
Introduction of Ophthalmia neonatorum Ophthalmia neonatorum defines as any infection of...
Introduction of Ophthalmia neonatorum Ophthalmia neonatorum defines as any infection of...
